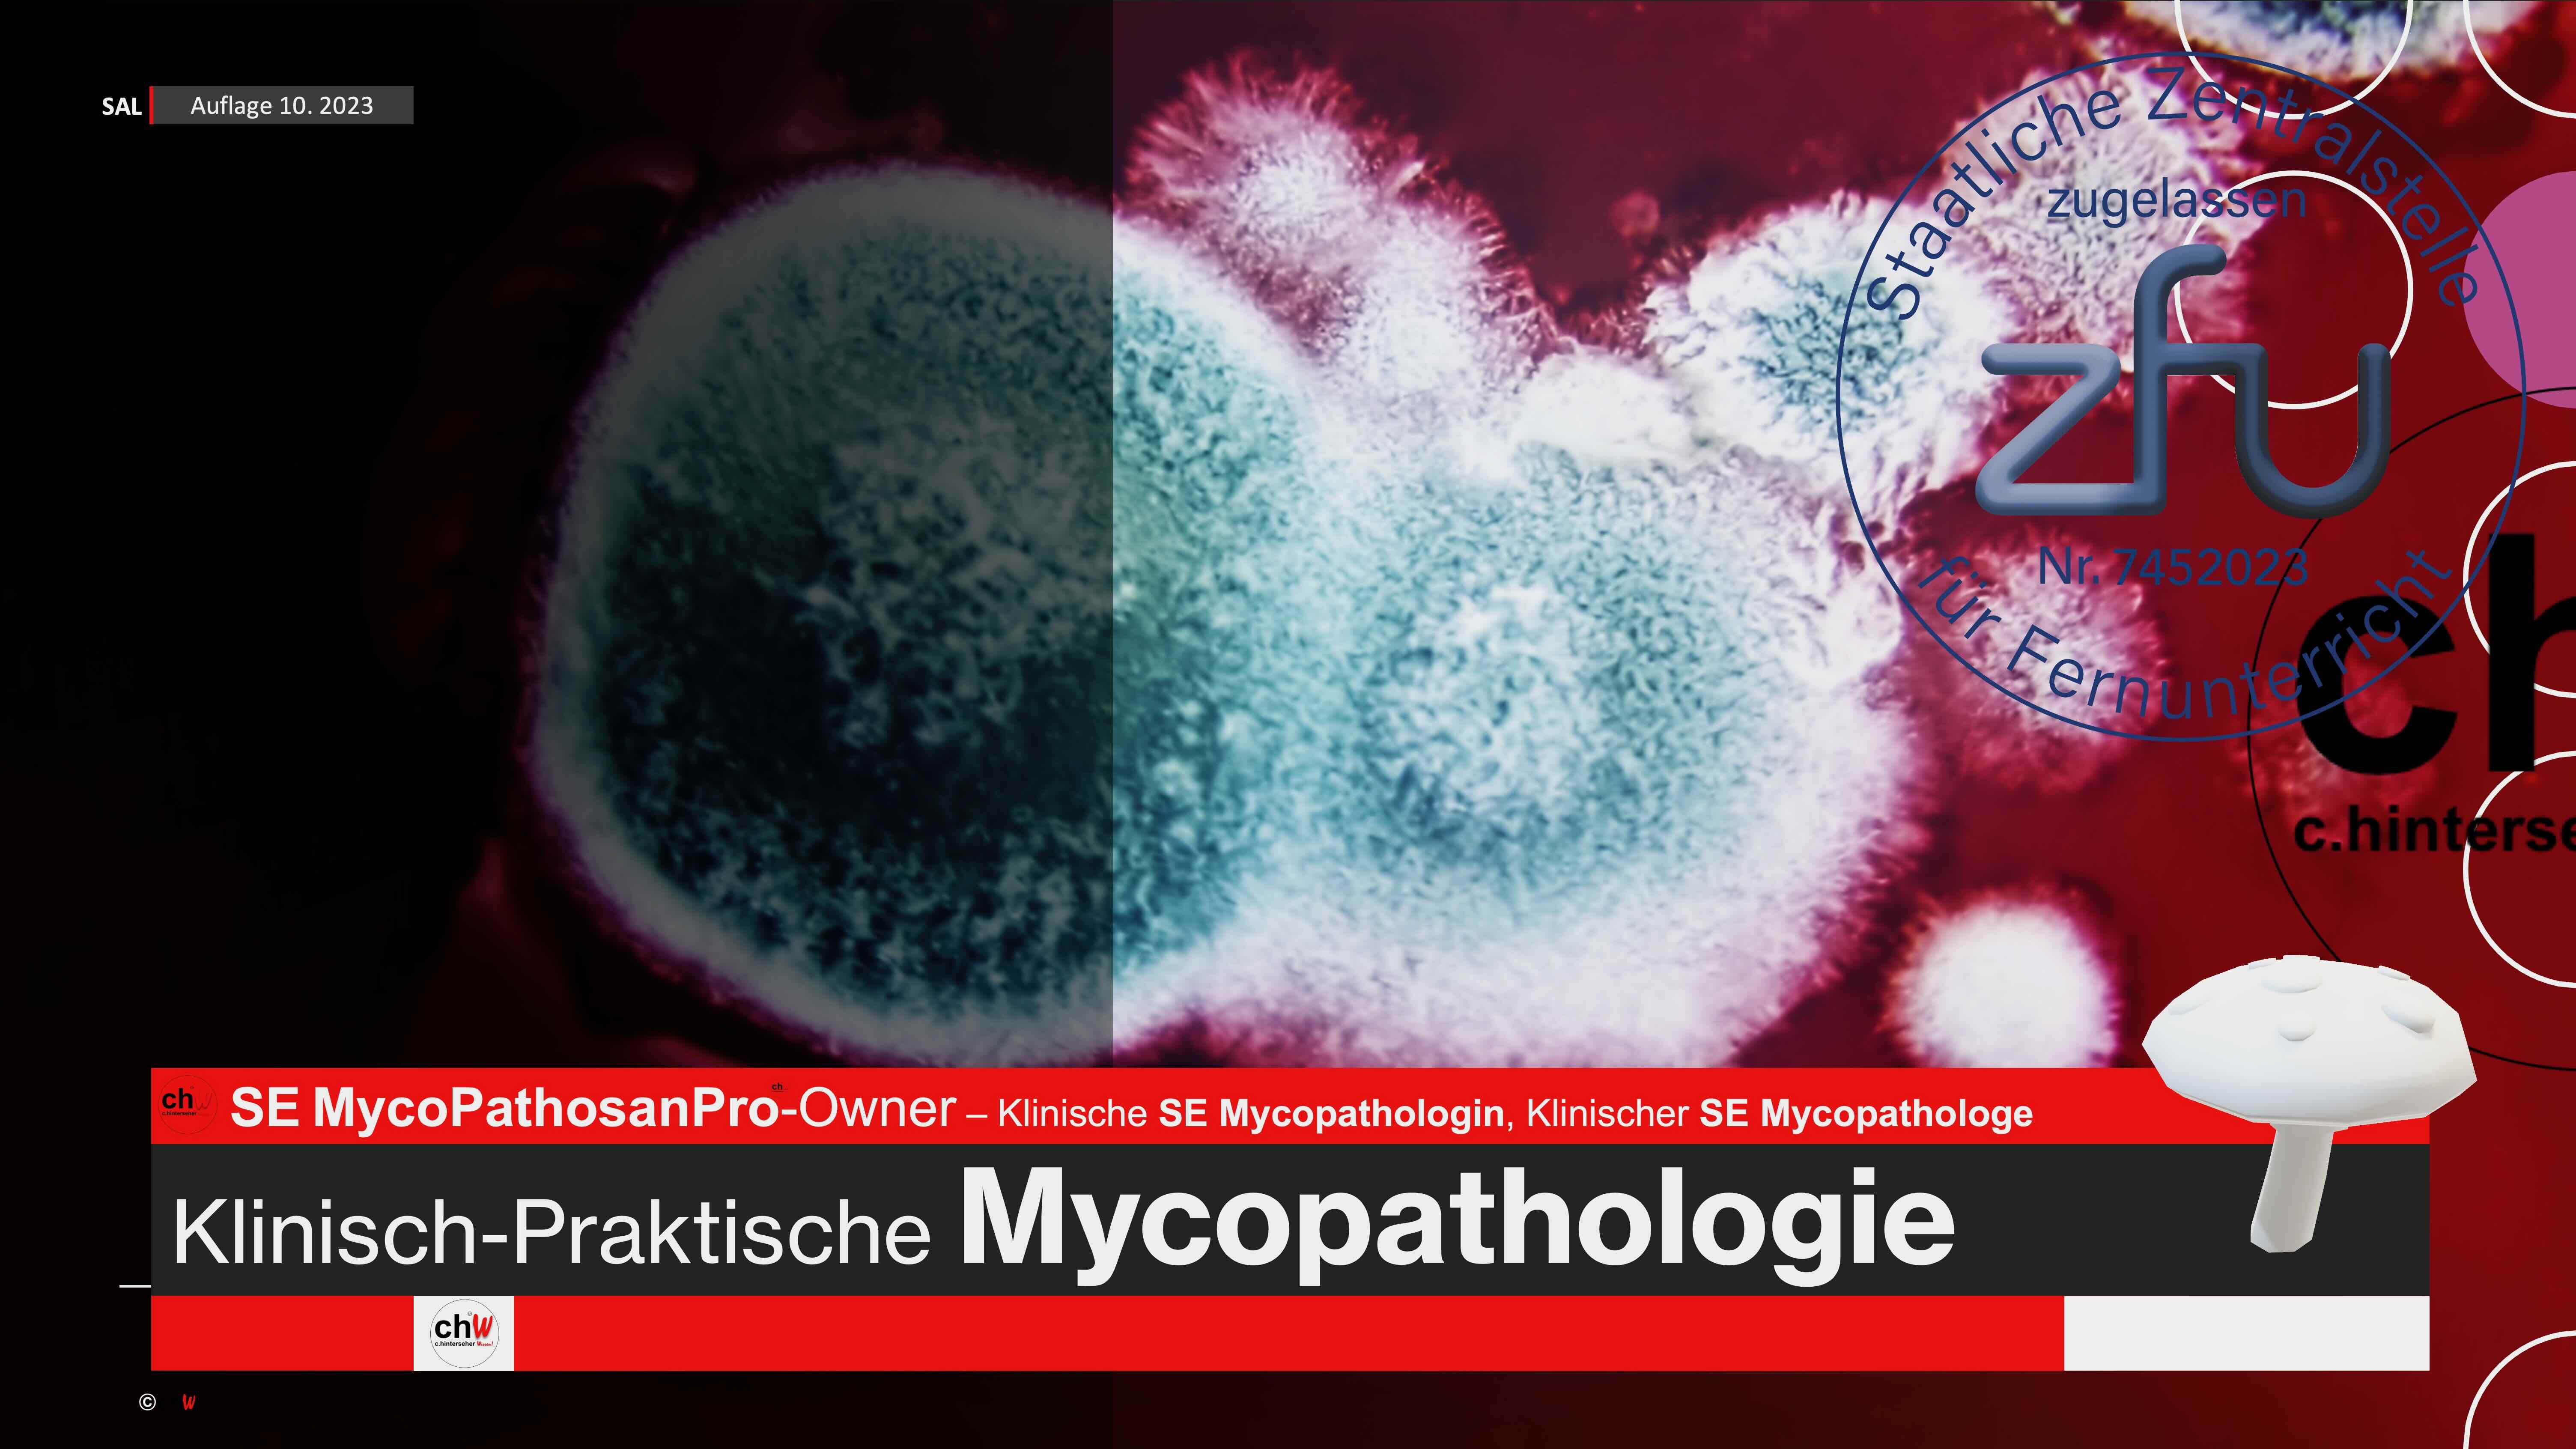

SE vVSPro veterinary Vertebral Specialist Holistic Chiropraxis for Animals
SE vVSPro veterinary Vertebral Specialist Holistic Chiropraxis for Animals
540,00 € bis 702,00 €
professional Holistic Chiropraxis for Animals
ChiropraxisHumanmedizinHund, Katze, PferdKomplementärmedizinKomplementärmedizinManualtherapieManualtherapieMenschVeterinärmedizin
„Die Wirbelsäule ist der Kraftkern“, so lehrte es einst Daniel David PALMER interessierte Studentinnen und Studenten der Holistischen Chiropraxis. Die Columna vertebralis fungiert nicht nur als stabiles Stützelement unseres Körpers, sondern dient chiropraktisch Praktizierenden als initialer Ausgangspunkt für homöostasierende Anwendungen, die sich auf das gesamte Körpersystem ausbreiten.
Bereits in unserem Grundstudiengang ´ SE vVS veterinary Vertebral Specialist Holistic Chiropraxis for Animals` haben wir zahlreiche Wirkweisen der Holistischen Chiropraxis erarbeitet, doch wir wollen noch tiefer in das Verständnis des „Arbeitens mit der Hand“ (cheir, gr. Hand; praxis, gr. Handlung, Arbeit) eintauchen.
SE vVS veterinary Vertebral Specialist Holistic Chiropraxis for Animals` haben wir zahlreiche Wirkweisen der Holistischen Chiropraxis erarbeitet, doch wir wollen noch tiefer in das Verständnis des „Arbeitens mit der Hand“ (cheir, gr. Hand; praxis, gr. Handlung, Arbeit) eintauchen.
Die Wirbelsäule erreicht bereits während ihrer embryofetalen Entstehung eine Bedeutung, die beinahe einem „Alles oder Nichts“-Prinzip gleicht. Denn die Chorda dorsalis, die Ur-Wirbelsäule, welche aus dem mittleren Keimblatt, dem Mesoderm, entsteht, ist der Ausgangspunkt für die Induktion aller Organe und orthopädischen Anteile von Tier und Mensch. Wie geht eine derartige Ausdifferenzierung vonstatten? Auch diese Frage wird während Ihres Studiums beantwortet. Für unser Verständnis und unsere chiropraktische Tätigkeit ist es von immensem Interesse, den Entwicklungsprozess in der frühen Fetalphase zu verstehen, denn Komplikationen in dieser Phase sind unter anderem die Folge zahlreicher Missbildungen der Wirbelsäule des Säugetiers.
Die Holistische Chiropraxis will über das Arbeiten an der Wirbelsäule ein neues Systemgleichgewicht initiieren. Dafür bedient sie sich verschiedener Übertragungs- und Kommunikationsprozesse, mit denen Sie sich in Ihrem Studium intensiv auseinandersetzen werden. Basierend auf diesem zentralen Grundverständnis werden Sie im Laufe Ihrer Chiropraxisausbildung in zahlreichen  vVSPro Konzepten die Theorie mit der Praxis verknüpft zur Anwendung bringen, sodass Sie stets nachvollziehen können, wo die Anwendung zur Wirkung kommt, welche positiven Auswirkungen zu erwarten sind und warum ein Wirkmechanismus in Gang gesetzt wird.
vVSPro Konzepten die Theorie mit der Praxis verknüpft zur Anwendung bringen, sodass Sie stets nachvollziehen können, wo die Anwendung zur Wirkung kommt, welche positiven Auswirkungen zu erwarten sind und warum ein Wirkmechanismus in Gang gesetzt wird.
So werden Sie bestens vorbereitet auf Ihre zukünftige Praxistätigkeit und können Ihren PatientInnen und / oder PatientInnenbesitzerInnen kompetent Rede und Antwort stehen.
Zur Beurteilung Ihrer praktischen Lernfortschritte bitten wir Sie, uns während Ihres Studiums Fotos und Videos Ihrer Anwendungen an Tier und / oder Mensch per E-Mail zu übermitteln. Ihre Daten werden dabei selbstverständlich DSGVO-konform behandelt.
Die Fernschule  bietet Ihnen eine intensive Begleitung während der gesamten Studienzeit und darüber hinaus. Wir sind jederzeit für Fragen ansprechbar. Senden Sie uns gerne eine E-Mail!
bietet Ihnen eine intensive Begleitung während der gesamten Studienzeit und darüber hinaus. Wir sind jederzeit für Fragen ansprechbar. Senden Sie uns gerne eine E-Mail!




 bietet diesen SE-Lehrgang auf Hochschulniveau an:
bietet diesen SE-Lehrgang auf Hochschulniveau an:
 Skilled Employee in veterinary Vertebral Specialist Pro
Skilled Employee in veterinary Vertebral Specialist Pro
( SE-vVSPro) – professional Holistic Chiropraxis for Animals –
SE-vVSPro) – professional Holistic Chiropraxis for Animals –
 bietet einen weiteren sog. „
bietet einen weiteren sog. „ SE-Lehrgang“ (Belegung der Basisversion
SE-Lehrgang“ (Belegung der Basisversion  SE vVS wird empfohlen)
SE vVS wird empfohlen)
Sie werden im Rahmen eines  SE-Lehrganges zum Titel-Abschluss „
SE-Lehrganges zum Titel-Abschluss „ Skilled Employee” (dt.: „
Skilled Employee” (dt.: „ Fachkraft für“) gefördert. Die Kennung „
Fachkraft für“) gefördert. Die Kennung „ SE“darf künftig als berufsbezogene fachspezifische Zusatzbezeichnung verstanden und öffentlich geführt werden.
SE“darf künftig als berufsbezogene fachspezifische Zusatzbezeichnung verstanden und öffentlich geführt werden.  bietet einen SE-Ausbildungsgang im Bereich Achsenskelett, Wirbelsäule, Stoffwechsel und Mobilisation in der Anwendung an Hund, Katze, Pferd und Mensch an.
bietet einen SE-Ausbildungsgang im Bereich Achsenskelett, Wirbelsäule, Stoffwechsel und Mobilisation in der Anwendung an Hund, Katze, Pferd und Mensch an.
Nun sind SIE gefragt, haben SIE Interesse, DIESEN SE-Lehrgang auf Hochschulniveau zu absolvieren, sich in diesem besonderen Fachsektor fort- und weiterzubilden?
AUSBILDUNGSBLOCK I:
Embryofetale und Evolutionäre Wirbelsäulen-Bedeutung
- „SPEMANN-MANGOLD-Organisator“ und chiropraktische Konsequenzen
- „Transformationsgesetz nach WOLFF“ und Therapiekonzepte der Chiropraxis
- FROSTs „Mechanostat-Theorem“ bei Hund, Katze, Pferd und Mensch
- chiropraktische Alltagsklinik und das „DAVIS-Gesetz“
- Biomechanik der Wirbelsäulen-Symphysen und chiropraktische Konzepte
- Age-Related Gene Expression (AGE) und chiropraktische Konzepte
Curriculum 1 (Zwischenprüfung)
Dauer: 45 Minuten
Medium: LIVE Online-Seminar (Webinar) über unser hausinternes, eigens programmiertes  LIVE… -Modul.
LIVE… -Modul.
Kosten: 25,00 Euro
15 Fragen; schriftliche Beantwortung innerhalb der 45 Minuten (Word-Dokument / E-Mail); E-Mail an info@c-hinterseher.de; bis 15 Minuten nach Terminende Anwesenheitspflicht(!)
AUSBILDUNGSBLOCK II:
ganzheitlich-chiropraktische Konzeptplanung
- „Von der Anamnese zum Konzept“
- Praxisplanung einzelner klinisch-praktischer Konzeptansätze
- spezielle Ansätze für Kleintier und Großtier
- Analytik und Chiropraxis
- Chiropraxis als Analyseverfahren für weitere manualpraktische Ansätze
- Chiropraxis: Mischansätze zu Physiotherapie, Osteopathie, allgemeine Mobilisation, Sporttherapie, Sportmedizin, Lymphdrainage
Curriculum 2 (Zwischenprüfung)
Dauer: 45 Minuten
Medium: LIVE Online-Seminar (Webinar) über unser hausinternes, eigens programmiertes  LIVE… -Modul.
LIVE… -Modul.
Kosten: 25,00 Euro
15 Fragen; schriftliche Beantwortung innerhalb der 45 Minuten (Word-Dokument / E-Mail); E-Mail an info@c-hinterseher.de; bis 15 Minuten nach Terminende Anwesenheitspflicht(!)
AUSBILDUNGSBLOCK III:
Chiropraxis und Internistik
- Begriff und Bedeutung des „Metabolismus“
- Detaillierte Ansatzplanung zu Stoffwechselkonzepten
- Chiropraktische Interaktion bei Endocrinopathien: Hypo- / Hyperthyreose, CUSHING-Pathologien (PPID), ADDISON-Krise, Diabetes mellitus, Diabetes insipidus
- metabolische Mechanismen und Theoreme im Zusammenhang mit manualpraktischen Techniken und Causalansätzen
Curriculum 3 (Zwischenprüfung)
Dauer: 45 Minuten
Medium: LIVE Online-Seminar (Webinar) über unser hausinternes, eigens programmiertes  LIVE… -Modul.
LIVE… -Modul.
Kosten: 25,00 Euro
15 Fragen; schriftliche Beantwortung innerhalb der 45 Minuten (Word-Dokument / E-Mail); E-Mail an info@c-hinterseher.de; bis 15 Minuten nach Terminende Anwesenheitspflicht(!)
AUSBILDUNGSBLOCK IV:
Chiropraxis und Onkologie
- basismedizinisches Onkologie-Verständnis
- Chiropraxis zur Begleitung onkologischer Pathologien
- Kontraindikationen und Ausschlüsse
- Indikationen und Interaktionen
- chiropraktische Cytostase- und Bestrahlungs-Begleitung
Curriculum 4 (Zwischenprüfung)
Dauer: 45 Minuten
Medium: LIVE Online-Seminar (Webinar) über unser hausinternes, eigens programmiertes  LIVE… -Modul.
LIVE… -Modul.
Kosten: 25,00 Euro
15 Fragen; schriftliche Beantwortung innerhalb der 45 Minuten (Word-Dokument / E-Mail); E-Mail an info@c-hinterseher.de; bis 15 Minuten nach Terminende Anwesenheitspflicht(!)
Gesamt- und Abschlussprüfung
Dauer: 3x 45 Minuten
Medium: Online-Seminar (Webinar) über unser hausinternes, eigens programmiertes  LIVE… -Modul.
LIVE… -Modul.
Kosten: 45,00 Euro
45 Fragen
schriftliche Beantwortung innerhalb der 3x 45 Minuten (Word-Dokument / E-Mail); E-Mail an info@c-hinterseher.de bis 45 Minuten nach Terminende; LIVE-Anwesenheitspflicht(!) zu den Prüfungsterminen
Sie müssen angemeldet sein, um eine Bewertung abgeben zu können.
Das könnte Ihnen auch gefallen …
-

 SE vBS veterinary Bone Specialist midi 24 Holistic Osteopathy for AnimalschW SE vBS veterinary Bone Specialist midi 24 Holistic Osteopathy for Animals540,00 € bis 702,00 €VK8S6
SE vBS veterinary Bone Specialist midi 24 Holistic Osteopathy for AnimalschW SE vBS veterinary Bone Specialist midi 24 Holistic Osteopathy for Animals540,00 € bis 702,00 €VK8S6Skilled Employee in veterinary Bone Specialist, Holistische Osteopathie und ihre Methoden für den Hund, die Katze, das Pferd, den Wiederkäuer, das Schwein und den Menschen theoretisch und praktisch angeleitet lernen.
- chW SE vBS veterinary Bone Specialist midi 24 Holistic Osteopathy for Animals - 540,00 € bis 702,00 €
-

 SE vBS veterinary Bone Specialist Holistic Osteopathy for AnimalschW SE vBS veterinary Bone Specialist Holistic Osteopathy for Animals5.400,00 € bis 7.020,00 €VK8S3
SE vBS veterinary Bone Specialist Holistic Osteopathy for AnimalschW SE vBS veterinary Bone Specialist Holistic Osteopathy for Animals5.400,00 € bis 7.020,00 €VK8S3Skilled Employee in veterinary Bone Specialist, Holistische Osteopathie und ihre Methoden für den Hund, die Katze, das Pferd, den Wiederkäuer, das Schwein und den Menschen theoretisch und praktisch angeleitet lernen.
- chW SE vBS veterinary Bone Specialist Holistic Osteopathy for Animals - 5.400,00 € bis 7.020,00 €
-

 SE vVS veterinary Vertebral Specialist Holistic Chiropraxis for AnimalschW SE vVS veterinary Vertebral Specialist Holistic Chiropraxis for Animals540,00 € bis 702,00 €VK8S2
SE vVS veterinary Vertebral Specialist Holistic Chiropraxis for AnimalschW SE vVS veterinary Vertebral Specialist Holistic Chiropraxis for Animals540,00 € bis 702,00 €VK8S2Holistic Chiropraxis for Animals
- chW SE vVS veterinary Vertebral Specialist Holistic Chiropraxis for Animals - 540,00 € bis 702,00 €
-

 SE vST veterinary Sporttherapy Energetisch-Ganzheitliche SporttherapiechW SE vST veterinary Sporttherapy Energetisch-Ganzheitliche Sporttherapie5.400,00 € bis 7.020,00 €VK8S1
SE vST veterinary Sporttherapy Energetisch-Ganzheitliche SporttherapiechW SE vST veterinary Sporttherapy Energetisch-Ganzheitliche Sporttherapie5.400,00 € bis 7.020,00 €VK8S1Skilled Employee in veterinary Sporttherapy, ZFU zertifizierter Studiengang, ganzheitliche Sportmedizin und ihre Anwendungsmöglichkeiten theoretisch und praktisch angeleitet verstehen lernen.
- chW SE vST veterinary Sporttherapy Energetisch-Ganzheitliche Sporttherapie - 5.400,00 € bis 7.020,00 €

c.hinterseher-Wissen!
c.hinterseher-Wissen!

Bewertungen
Es gibt noch keine Bewertungen.